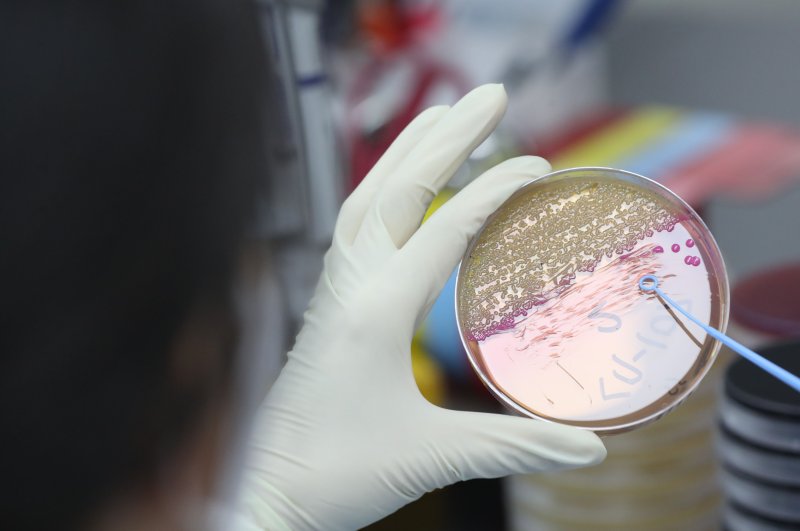

임상, 실무에서의 포용성 주제로 행사 진행
[파이낸셜뉴스] 보건복지부와 국가임상시험지원재단은 21일 동대문디자인플라자에서 '2025 세계 임상시험의 날' 행사를 개최했다.
세계 임상시험의 날은 영국 해군 군의관 제임스 린드가 괴혈병 치료를 위해 항해 중인 선원들을 대상으로 1747년 5월 20일에 최초의 근대적 임상시험 실시한 것을 기념해 지정됐다.
올해 임상시험의 날은 '임상시험 재고: 실무에서의 포용성'을 주제로 진행됐다.
이날 행사에는 국내 주요 제약사 및 병원 관계자, 환자단체 관계자 등 60여명이 참석해 임상시험 발전에 기여한 유공자 15명에 대해 보건복지부 장관 표창을 수여했다.
전남대학교병원 김병채 교수는 알츠하이머병 및 신경계 질환의 새로운 치료제 임상연구를 통해 고령 환자 등 소외된 집단의 임상시험 참여 확대에 대한 공로를 인정받았다.
한국신경내분비종양환우회 한명희 운영위원은 환자 참여자로서의 경험을 바탕으로 임상시험 정보 접근성과 참여 권리 보장에 기여해 수상했다.
표창 수여에 이어진 주제강연에서는 장관표창 수상자인 삼성서울병원 최병옥 교수가‘임상시험에서의 포용성’을 주제로 발표하며 임상시험 참여의 형평성과 대표성 확보의 중요성, 고령자 및 희귀질환자 등 소외 계층 참여 확대의 필요성을 강조했다.
정은영 복지부 보건산업정책국장은 “우리나라는 그동안 임상시험 역량을 꾸준히 강화시켜 글로벌 시장에서 선도적 입지를 확보해 왔다”면서 “고령자, 소아, 장애인, 희귀질환자 등 다양한 계층이 임상시험에서 배제되지 않고 안전하게 참여할 수 있도록 임상시험 전주기 지원체계 고도화, 데이터 기반 분산형 임상시험 인프라 구축, 연구자 중심 임상시험 활성화 등 다각적인 정책을 추진해 대한민국이 글로벌 바이오헬스 중심국가로 도약할 수 있도록 지속적으로 뒷받침하겠다”고 말했다.
박인석 국가임상시험지원재단 이사장은“포용적 임상시험이 우리나라 임상시험의 질을 한 단계 끌어올리는 계기가 되기를 바란다"면서 "앞으로도 다양한 계층의 참여를 독려할 수 있는 수요자 맞춤형 정보제공을 확대해 나가겠다”고 설명했다.
vrdw88@fnnews.com 강중모 기자
※ 저작권자 ⓒ 파이낸셜뉴스, 무단전재-재배포 금지

